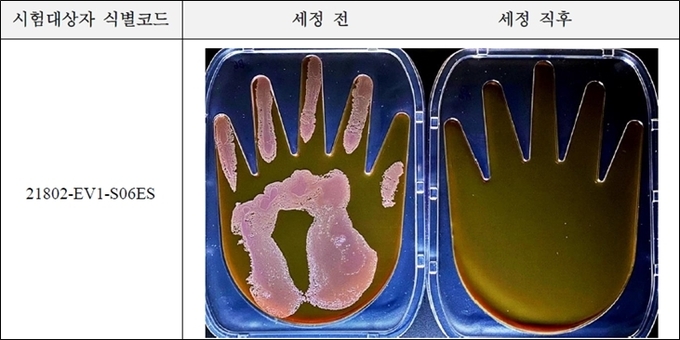

# 무알코올 천연식물 유래 항균 화장품 원료 'WFEC 2.0'
1. 소개
인간이 감염증에 걸리는 요인 중 대부분은 물건 등에 부착된 병원성 미생물(세균, 바이러스 등)이 손을 통해 눈이나 코, 입으로부터 체내로 들어가는 것이다. 많은 병원성 미생물은 난간, 엘리베이터의 버튼, 문의 손잡이 등을 통해 손에서 손으로 전달되며 감염을 확대시킨다. 따라서 적절한 타이밍에 손위생(손씻기)을 하는 것은 자기 자신을 병원성 미생물로부터 지킴과 동시에 감염 확대를 방지하는데도 상당히 유효한 수단이다.
세계보건기구(WHO)는 감염을 예방하기 위한 기본적인 대책으로 손 씻기나 손소독액을 사용한 손위생을 권장하고 있으며 앞으로도 일상생활에서의 손위생에 대한 의식은 계속 높아질 것으로 생각한다1).
그러나 잦은 손씻기나 손소독은 감염 예방 차원에서 상당히 유효하면서도 피부에 대해 거칠어짐 등의 악영 향을 준다는 문제가 있다. 손의 거칠어짐이란 일반적으로 피부가 수분을 잃고 건조와 더불어 부스러기나 균열, 염증이 생긴 상태인 것으로 여겨진다.
피부를 세정제로 씻으면 피부 표면의 오염물이나 미생물 뿐 아니라 동시에 각질층 표면의 피지막도 제거된다. 보통 피지막은 피지선의 피지 공급에 의해 몇시간 정도면 회복되지만 피지막이 회복되지 않은 상태에서 계속해서 세정하면 각질층 안의 NMF(Natural Moisturizing Factor)나 세포간지질까지도 상실되어 각질층의 장벽 기능이 현저하게 저하된다2)3).
특히 손은 몸 중에서도 가장 외부 환경과의 접촉 빈도가 많으며 항상 바깥 환경과 물리적 자극에 노출되어 있는 부위임에도 불구하고 피지선이 적기 때문에 원래부터 건조하거나 거칠어지기 쉽다. 알코올이 함유된 세정제는 각질층에 도달한 알코올이 증발할 때 각질층 내의 수분도 함께 증발해 각질층은 급격한 건조 상태가 되어 피부의 과건조를 가속시키는 요인이 된다4).
알코올을 함유한 세정제의 피부 거칠어짐에 대한 대비책으로 보습성분이 배합된 세정제나 세정제 사용 후 보습크림 사용 등이 제안되고 있다. 그러나 근본적인 해결책은 무알코올 항균세정제를 개발해 손 등의 피부 건강을 유지하는 것이다.
고추냉이는 우리나라 자생종인 Wasabia koreana Nakai와 일본이 원산지인 Wasabia japonica Matsum, 그리고 서양고추냉이인 Horseradish(Armoracia rusticana)로 분류되어 있다. 여러 가지 ITCs 화합물들이 미생물의 생장 억제 효과를 갖고 있는데 ITCs의 주성분은 Allylisothiocyanate(AIT)이며 고추냉이에서 추출된 정유의 대부분을 차지하고 있다5).
서양고추냉이(Armoracia rusticana) 뿌리추출물에 비해 고추냉이(Wasabia japonica Matsum) 뿌리추출물이 항균 효과의 주성분인 Allylisothiocyanate를 많이 갖는 것으로 확인됐다6). AIT는 맛과 향으로 인한 식욕과 소화촉진 작용 외에도 항균효과도 연구됐다7). 다양한 AIT 유도체의 시약으로 항균활성을 연구한 내용이며 실제 고추냉이 추출물이나 겨자추출물로 항균 능력을 확인한 균은 Vibrio균과 Helicobacter균, 구강유래 세균을 대상으로 항균 효과가 보고된 바 있다8)9).
본 연구에서는 고추냉이 아임계 복합추출물에 발효 전환기술을 적용해 그람양성균과 그람음성균과 효모균에 대한 항균활성을 지닌 천연소재(WFEC2.0)을 유효성분으로 하는 All-in-one 컨셉의 항균 세정제를 개발해 인체 적용 피부자극시험과 항균임상을 진행했다.
2. 인체적용 피부자극시험
2-1. 시험시료 및 임상시험기관
WFEC2.0 소재를 4% 첨가한 세정제 완제품 제형을 제조해 공인시험기관인 KTR(한국화학시험연구원)에 의뢰해 인체적용 패치테스트를 통한 피부자극시험을 진행했다.
2-2. 인체적용시험지침 및 시험대상자
기능성 화장품 심사에 관한 규정(식품의약품안전처 고시 제2019-47호)에 따라 시험진행, 자료수립 했으며 International Contact Dermatitis Research Group(ICDRG) 판정기준에 따라 결과를 분석했다. 목표한 시험대상자 수는 만 20~59세 이하의 건강한 성인 남녀 32명으로, 식품의약품안전처 ‘기능성화장품 심사에 관한 규정’의 시험방법에 근거했고 중도탈락자를 예측해 산출했다.
2-3. 시험평가방법 및 시험결과
시험부위 육안평가는 International Contact Dermatitis Research Group (ICDRG) 판정기준에 따라 실시했다. ICDRG 판정기준은 표1과 같다.
표1 ICDRG 판정기준

산출된 피부반응도를 기준으로 피부자극도를 무자극, 미자극, 경자극, 중자극, 강자극 등으로 판정한다. 인체적용 패치테스틀 통한 인체피부 일차자극시험 진행결과 ‘무자극’ 판정을 받았다.
3. 인체적용 항균시험
3-1. 시험시료 및 임상시험기관
WFEC2.0 소재를 4% 첨가한 세정제 완제품 제형을 제조해 공인시험기관인 GMRC(글로벌의학연구센터)에 의뢰해 인체적용 항균 임상시험을 진행했다.
3-2. 인체적용시험지침 및 시험대상자
기능성화장품 심사에 관한 규정(식품의약품안전처 고시 제2019-47호)에 따라 시험진행, 자료수립 했으며 목표한 시험대상자 수는 만 20~59세 이하의 건강한 성인남녀 20명으로, 식품의약품안전처 ‘기능성화장품심사에 관한 규정’의 시험방법에 근거했고 중도탈락자를 예측해 산출했다.
3-3. 시험평가방법 및 통계분석
시험대상자의 한쪽 손에 대장균[Escherichia coli (ATCC #11229)] 혹은 황색포도상구균 [Staphylococcus aureus (ATCC #6538)] 혹은 칸디다균 [Candida albicans (ATCC #MYA-2876)]을 도포해 각균의 hand plate에 가볍게 3초간 접촉시켰다. 시험제품을 균을 도포한 손바닥 위에 2~3회 펌핑해 1분간 거품을 내어 마사지 하듯 닦아주었다. 1분간 깨끗하게 헹구어 세정한 후 동일하게 각균의 hand plate에 손을 가볍게 3초간 접촉시켰다. 균이 접촉된 hand plate는 37℃에서 24시간 동안 배양하고 이후 기기평가를 진행했다.
균의 집락 면적은 디지털카메라(DSLR)로 촬영하고, Image program (National Institutes of Health, Maryland, USA)을 이용해 측정한다. 시험제품 사용 전(세정 전)과 시험제품 사용 직후(세정 후) 시험부위(한쪽 손바닥)를 hand plate에 접촉해 배양된 균의 사진을 촬영하고 균의 집락 면적을 측정해 균 저해율을 평가자료로 활용했다.
통계분석은 IBM SPSS statistics 25.0 프로그램을 이용해 검증하고 시험제품 사용 전 및 사용 직후 유의성 여부를 가설 평균차 5% (p<0.05)로 확인했다. 정규성 검정 후 정규성 검정만족 여부에 따라 Wilcoxon signed rank test(비모수적방법)를 통해 유의성 여부를 확인했다.
3-4. 인체적용 항균 시험결과
시험제품 사용 전, 사용 직후 대장균, 황색포도상구균, 칸디다균의 집락 면적을 측정해 균 저해율을 분석한 결과는 표2와 같다. 또한 피험자 손에 도포한 대장균 집락 대표 이미지는 그림1과 같다.
표2 시험제품에 대한 균 저해율 (%)

그림1 피험자의 손에 도포한 대장균 집락 대표이미지
시험제품 사용 전, 사용 직후 황색포도상구균과 칸디다균의 군락 대표 이미지는 각각 그림2와 그림3과 같다.
그림2 피험자의 손에 도포한 황색포도상구균 집락 대표이미지

그림3 피험자의 손에 도포한 칸디다균 집락 대표이미지

WFEC2.0 개발소재를 유효성분으로 사용한 Allin-one 제품을 대상으로 외부공인기관에서 인체적용 항균 시험을 진행한 결과, 대장균, 황색포도상구균, 칸디다균에 대해서 항균력 99% 이상을 확인했다.
4. 정리
WFEC 2.0은 강력한 항균, 항진균 활성을 갖는 천연물을 이용해 아임계 추출 공법과 생물전환 공법으로 제조되어 관능적 영향을 최소화한 천연 항균, 항진균 소재이다. 또 화장품 항균세정제, 치약, 가글, 손소독제 제형에 적용시 항균 활성이 우수해 천연 기능성화장품 소재, 천연 치약과 천연 가글, 천연 손소독제로서의 가능성과 산업적 활용가치가 우수하다.
5. 제품정보
・ INCI : Lactobacillus/Wasabia japonioca Root Ferment Extract, Brassica Oleracea Italica (Broccoli) Extract, Glycerin, Water
・ Apperarance : Yellow liquid
・ Dosage : 3~4%
・ Solubility : Water soluble
・ pH : 3.8±1.0 (25℃, 2% Solution)
・ Authentication : HALAL, ECOCERT RM
문의처
(주)비에스티
주소 : 성남시 중원구 사기막골로45번길 14우림라이온스밸리 2차 B동 B109호
TEL : 031-745-5885
E-mail : bst_cos@naver.com
홈페이지 : www.ibst.kr
Copyright ⓒ Since 2012 COS'IN. All Right Reserved.
#코스메틱저널코리아(CJK) #화장품 #코스메틱 #2022년6월호 #화장품연구개발마케팅전문저널 #기술정보 #최신연구 #비에스티 #천연물유래항균항진균소재 #무알코올천연식물유래 #항균화장품원료 #WFEC2.0 #고추냉이(Wasabia japonica Matsum)뿌리추출물 #All-in-one컨셉 #항균세정제개발 #기능성화장품 #천연치약 #천연가글 #천연손소독제